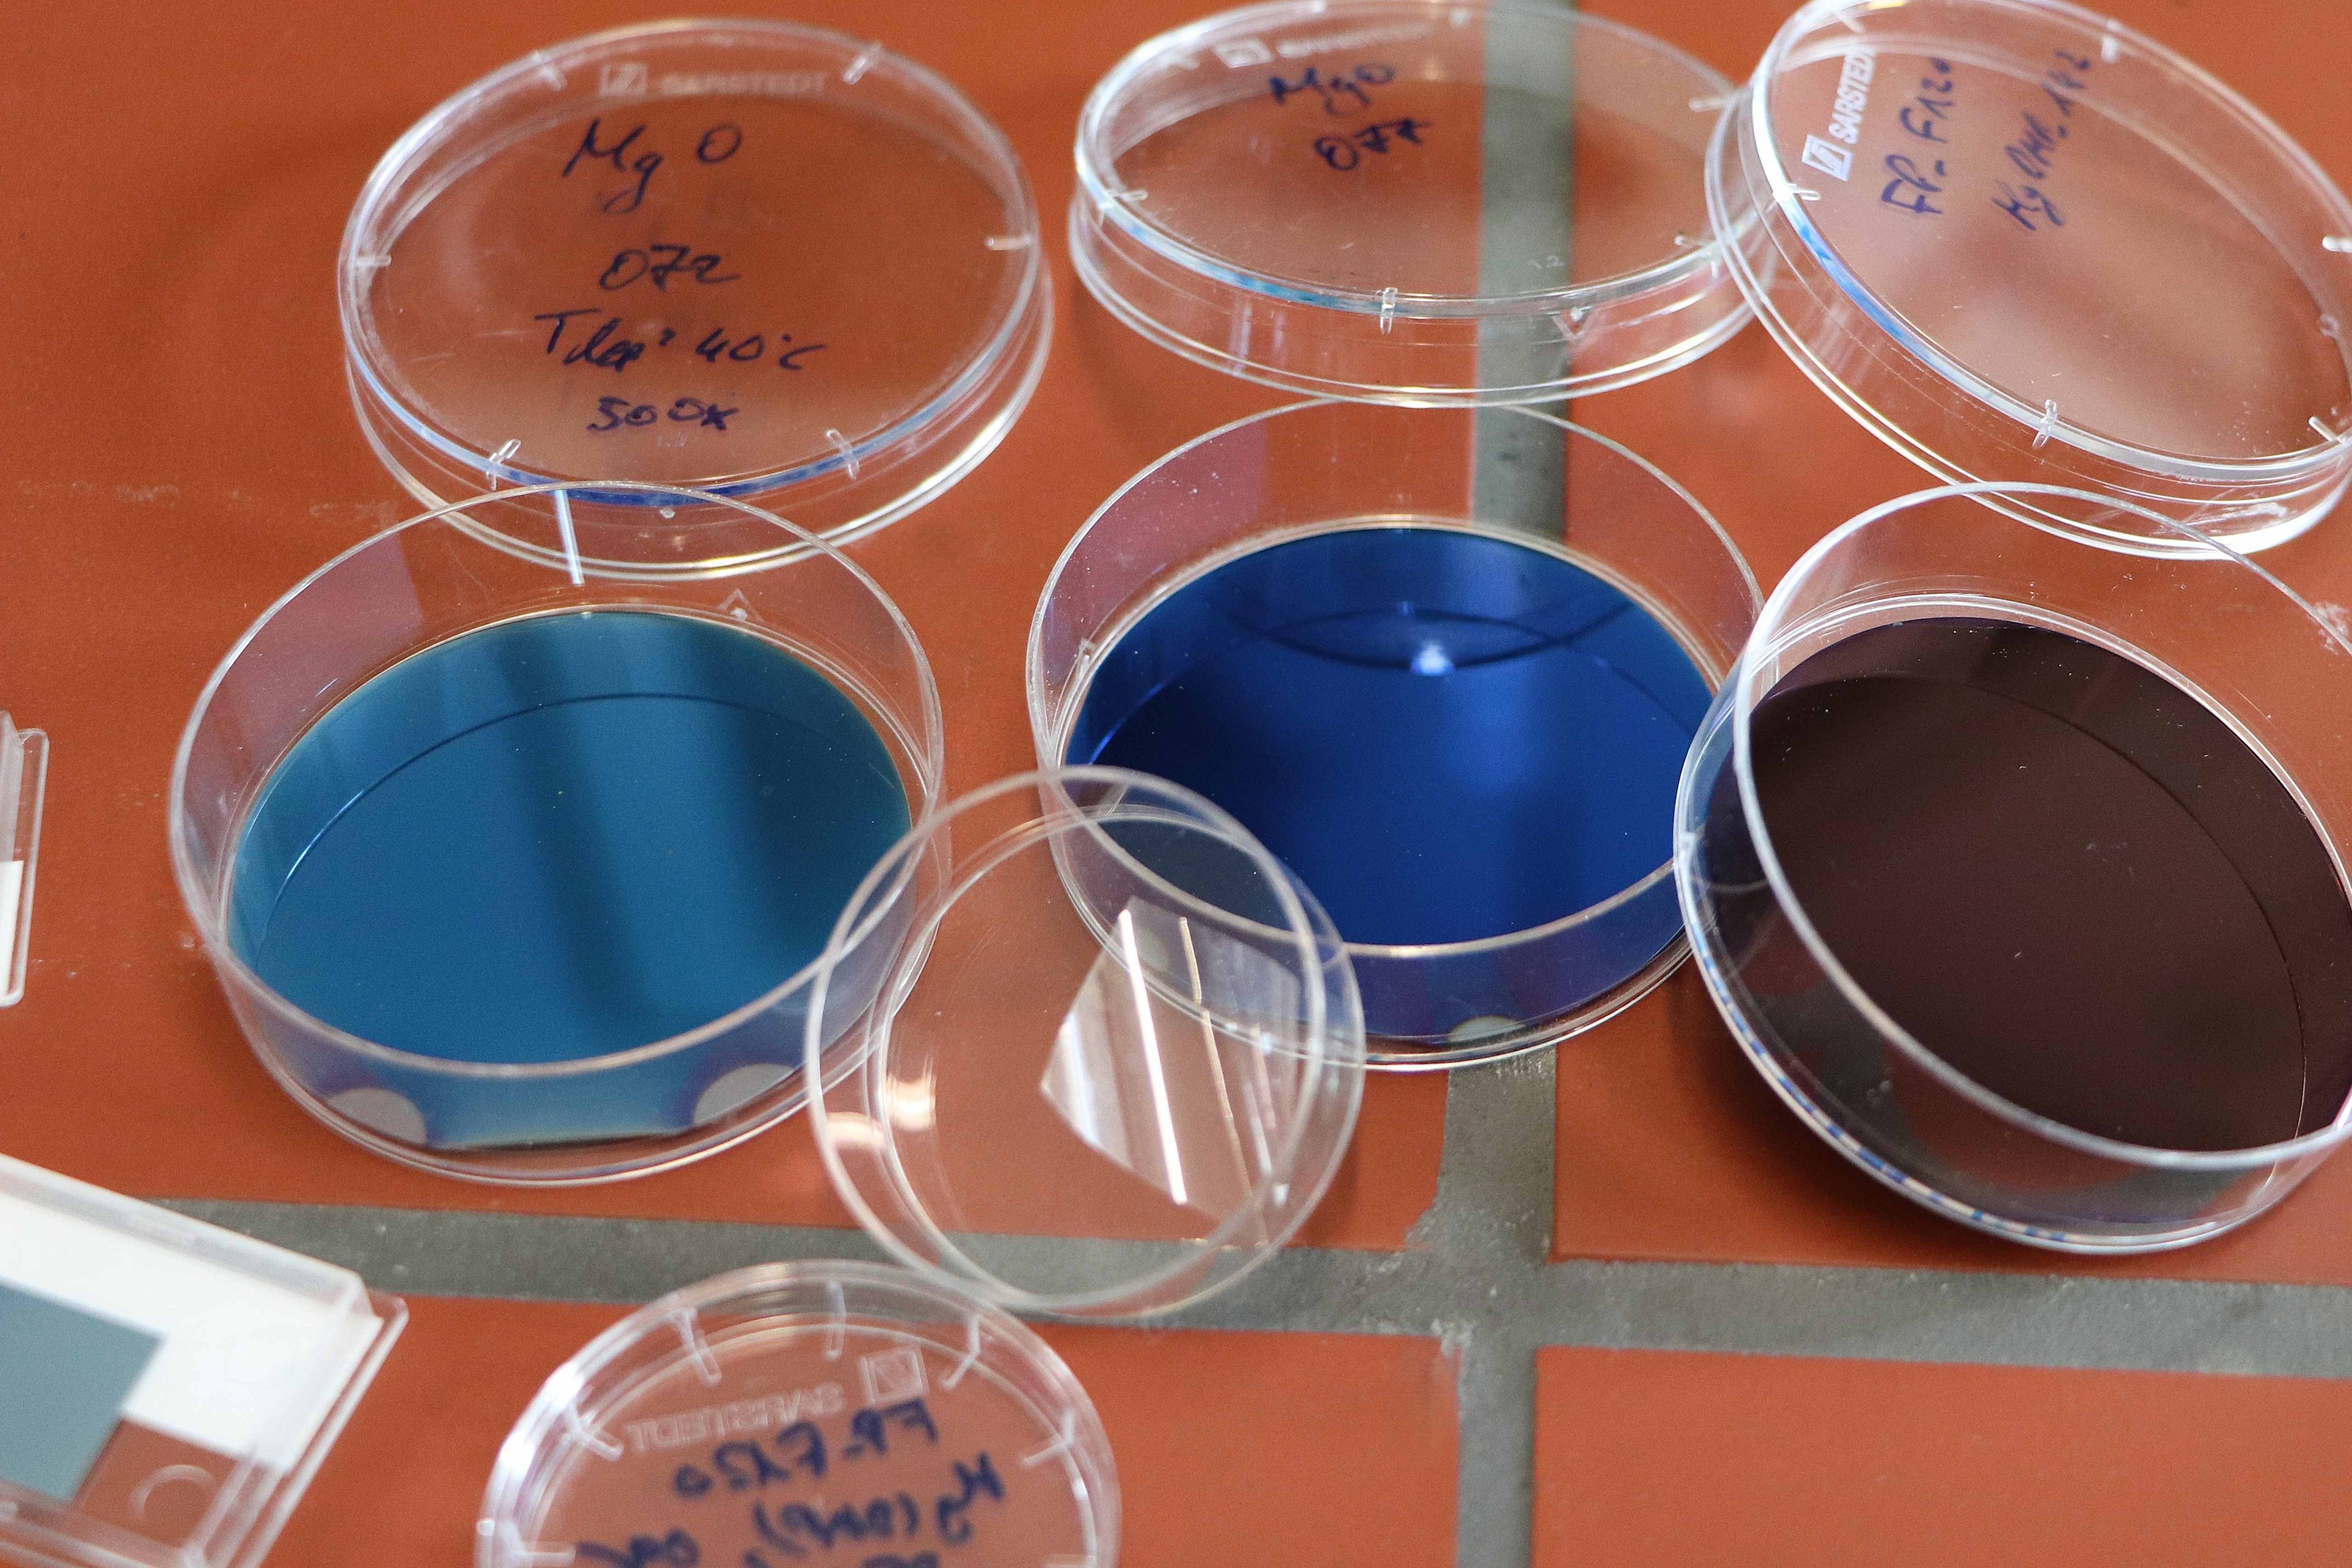

An interdisciplinary research team has developed a novel magnesium precursor that, for the first time, enables the deposition of ultrathin magnesium oxide (MgO) films at previously unattainable low temperatures using atomic layer deposition (ALD).
In thin film technology, precursors play a crucial role. These specially designed chemical compounds act as the starting materials for film growth. Once introduced into the reaction chamber, they react in strictly controlled cycles with a second reactant. This results in extremely thin, uniform, and defect-free films – layer by layer at the molecular level.
Florian Preischel, doctoral researcher at the Leibniz Institute for Solid State and Materials Research Dresden (IFW Dresden) and Ruhr University Bochum (RUB), has combined all the key properties required for successful ALD in his work. The new precursor is volatile, thermally stable, and highly reactive – yet, unlike earlier compounds, it is not pyrophoric in air. This makes it safer and easier to handle while also allowing for larger-scale production – an important step toward industrial applicability.
“With the new Mg precursor, we were able to deposit uniform magnesium oxide films at temperatures ranging from just 30 to 260 °Celsius – a significant advancement over previous approaches. This paves the way for new applications, such as coating temperature-sensitive materials like polymer foils or flexible electronics,” explains Preischel.
The findings have been published in the reputable Journal of the American Chemical Society. In 2024, Preischel also received the Dr. Tuomo Suntola Prize at the International ALD/ALE Conference in Helsinki for this work.
Magnesium oxide is a readily accessible, non-toxic, and bio-compatible material. It is suitable for a wide range of applications – from protective barrier coatings and implant coatings to oxide barriers in magnetic tunnel junctions (MTJs) and innovative memory technologies such as magnetoresistive random access memory (MRAM). The next step is to thoroughly test the functionality of MgO films in practical settings, especially in electronics and biomedical coatings.
Since her appointment at IFW Dresden in January 2024, Prof. Anjana Devi, who supervises Preischel’s doctoral work, has been establishing a new competence center for atomic layer deposition. Her efforts are expanding IFW’s activities in materials chemistry, enhancing international visibility and networking opportunities.
Preischel’s work exemplifies progress in this field and highlights Dresden’s strong potential as a hub for future key technologies.
Original Publication:
J. Am. Chem. Soc. 2025, 147, 35, 31764–31778
https://doi.org/10.1021/jacs.5c08514
Contact
Scientific contact:
Florian Preischel
f.preischel[at]ifw-dresden.de
Prof. Dr. Anjana Devi
a.devi[at]ifw-dresden.de
Press contact:
Patricia Bäuchler
Science Communication
p.baeuchler[at]ifw-dresden.de